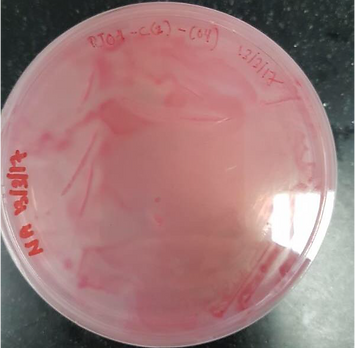
Slide 12 (2).png

RESEARCH CONDUCTED
MICROBES ISOLATION FROM SOIL AND SEA WATER
-
To date, more than 700 colonies of bacteria and yeast were isolated. Glycerol stock was kept at -80°C until further use.
-
The isolated colonies shown unique characteristics and has potential for further study.
.png)
.png)
.png)
Bacterial isolated from Jemuruk Island required multiple subcultures. At least four subcultures were carried in order to get single isolated colony.
.png)
.png)
Halo or zone of inhibition around the bacteria colony can be seen. A promising bacteria for further investigation.
The whole plate changes to pink due to the metabolites activity of a particular bacteria. Currently, we are still doing further investigation on it.
.png)
.png)
.png)

.png)
.png)

PRELIMINARY SCREENING OF MICROBIAL PRODUCING ANTIMICROBIAL AGENT(S)
Workflow:
.png)
.png)
.png)



RESULT : MICROBIAL PRODUCING ANTIMICROBIAL AGENT(S) PRELIMINARY SCREENING
Around 500 isolated single colonies were selected for antimicrobial preliminary screening. E. coli, Bacillus subtilis and Pseudomonas aeruginosa were used as test microorganism. Paper disc (Whatman paper) dropped with 10-μl of 1-day old isolated culture was placed on test microorganism lawn on Tryptic Casein Agar (TSA). The culture was incubated at 30°C for 24 hrs. Isolates which potential to inhibit the test microbes was observed as clear zone around paper disc. Table below is show the total number of isolated culture gave the clear zone towards test microorganism.

PRELIMINARY SCREENING OF INDUSTRIAL MICROBIAL ENZYMES
Candidate of enzyme: Lipase/Esterase & Protease
Workflow:
TBA (for Lipase/esterase) and SMA (for Protease) plate assay were conducted at 37⁰C for 24-48 hrs.
Halo zone of each isolates were observed after 48hrs.
Results:
TBA Plate Assay
.png)
.png)
.png)
.png)
SMA Plate Assay

Enzyme Screening Summary:


PROTEOMICS PROFILING OF CULTIVABLE MICROORGANISMS
-
We obtained preliminary results of expressed proteins in secreted and pellet cells of cultivable microorganisms.
-
The samples were from soils and sea water. The results can be used as reference for future study.
-
However, it is not conclusion. Further investigation need to be carried out.
Table 1. Snapshot of proteins expressed from cultivable microbes of sea water sample.

Table 2. Snapshot of proteins expressed from cultivable microbes of soil sample.

Table 3. Snapshot of proteins expressed from secretome of cultivable microbes of sea water sample

Table 4. Snapshot of proteins expressed from secretome of cultivable microbes of soil sample

EXPECTED OUTPUT FROM PHASE 1 OF MoJI PROJECT
-
Taxonomic composition of microbial communities in Jemuruk Island. Hopefully, microbial communities could be reintroduced during reforestation.
-
To identify possible secondary metabolism pathways in the soil microbial communities using in silico approaches.
-
Microbes could be used as effective microorganisms for bio-fertilizer.
-
Candidates of natural products for novel pharmaceuticals applications.
-
Metabolites products as a candidate for commercial value as a food supplement for human and as food additives for animals and fish.
